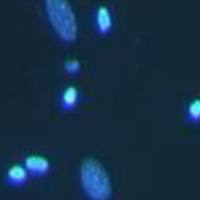
细胞凋亡Hoechst染色

万千商家帮你免费找货
0 人在求购买到急需产品
- 详细信息
- 文献和实验
- 技术资料
- 提供商:
菲优特检测
- 服务名称:
细胞侵袭实验,细胞实验外包
- 规格:
样

一、实验目的
细胞侵袭实验旨在研究肿瘤细胞或活细胞突破细胞外基质(ECM)屏障的能力,模拟体内肿瘤转移或炎症反应中细胞穿越基底膜的过程。通过量化细胞侵袭能力,评估肿瘤的恶性程度、药物疗效或基因调控对细胞行为的影响,为癌症治疗、药物研发及基础研究提供关键数据支持。
二、技术原理
细胞侵袭的生物学机制
细胞侵袭涉及细胞外基质(ECM)的降解与细胞迁移的协同作用。肿瘤细胞通过分泌基质金属蛋白酶(MMPs)等蛋白酶降解ECM成分(如胶原蛋白、层粘连蛋白),随后通过伪足延伸、细胞骨架重组等机制穿越基质屏障。
实验模型设计
- Transwell小室:上下室由聚碳酸酯膜分隔,膜上涂覆基质胶(如Matrigel)模拟ECM。
- 趋化因子梯度:下室加入含血清或趋化因子的培养基,诱导细胞定向迁移。
- 定量分析:通过计数穿透基质胶并黏附于膜下表面的细胞数量,评估侵袭能力。
三、实验流程
基质胶铺板
- 基质胶(如Matrigel)4℃解冻,按比例(如1:8)与无血清培养基混合。
- 每孔加入50-100μL混合液至Transwell上室,37℃孵育1-3小时使其聚合。
细胞准备
- 消化细胞,无血清培养基重悬,调整密度至1×10⁵-5×10⁵ cells/mL。
- (可选)饥饿处理(无血清培养12-24小时)增强侵袭能力。
接种与培养
- 上室加入200μL细胞悬液,下室加入600μL含10% FBS的培养基。
- 37℃、5% CO₂培养24-72小时(时间需预实验优化)。
固定与染色
- 棉签擦除上室未侵袭细胞,4%多聚-甲醛固定20分钟。
- 结晶紫染色15-30分钟,PBS清洗后晾干。
计数与统计
- 显微镜下随机选取5-10个视野,计数膜下表面细胞。
- 使用ImageJ等软件辅助分析,计算侵袭细胞数或相对侵袭率。
四、仪器及试剂
主要仪器
- CO₂培养箱、倒置显微镜、细胞计数仪、移液器、24孔板、Transwell小室(8μm孔径)。
关键试剂
- 基质胶(如Matrigel)、无血清培养基、含FBS培养基、4%多聚-甲醛、结晶紫染液、胰酶、PBS。
五、送检及交付标准
送检要求
- 提供细胞类型、来源、处理方式(如转染、药物处理)及实验目的。
- 明确检测指标(如侵袭细胞数、相对侵袭率)及对照组设置。
交付内容
- 原始数据(显微镜图像、计数结果)。
- 统计分析报告(包括均值、标准差、P值)。
- 实验结论与建议(如药物对侵袭能力的影响)。
质量标准
- 重复实验≥3次,确保数据可靠性。
- 对照组(如空白组、阳性对照组)设置合理,结果差异显著(P<0.05)。
六、注意事项
实验操作
- 基质胶需冰上操作,避免胶体凝固。
- 铺胶时避免气泡产生,确保膜表面均匀覆盖。
- 细胞接种密度需优化,过高导致膜孔堵塞,过低影响统计准确性。
培养条件
- 培养时间需预实验确定,不同细胞侵袭能力差异显著。
- 保持培养箱湿度(>90%),防止边缘效应。
结果分析
- 排除非特异性黏附细胞(如通过二次清洗验证)。
- 结合Western Blot检测MMPs表达或划痕实验验证迁移能力,增强结论可信度。
七、应用领域
肿瘤研究
- 评估肿瘤细胞的转移潜能,筛选抗侵袭药物靶点。
- 研究上皮-间质转化(EMT)相关基因(如Snail、Twist)对侵袭的影响。
药物研发
- 检测新型抗癌药物(如MMP抑制剂)对细胞侵袭的抑制效果。
- 评价中药提取物或纳米材料的抗转移活性。
炎症与免疫
- 研究巨噬细胞、中性粒细胞等免疫细胞在炎症部位的侵袭行为。
- 模拟病原体(如细菌、病毒)感染过程中的细胞侵袭机制。
组织工程
- 评估种子细胞在三维支架中的侵袭与整合能力,优化组织修复策略。
总结
细胞侵袭实验通过模拟体内ECM屏障,为研究肿瘤转移、药物疗效及细胞行为提供了重要工具。实验设计需严格控制变量(如基质胶浓度、培养时间),结合多维度分析(如基因表达、蛋白活性)可显著提升结果可靠性。其应用广泛,涵盖肿瘤学、药理学、免疫学及再生医学等领域,为疾病机制解析与治疗策略开发提供了关键支持。

风险提示:丁香通仅作为第三方平台,为商家信息发布提供平台空间。用户咨询产品时请注意保护个人信息及财产安全,合理判断,谨慎选购商品,商家和用户对交易行为负责。对于医疗器械类产品,请先查证核实企业经营资质和医疗器械产品注册证情况。
文献和实验基于阻抗的rtca细胞分析技术应用--Transwell侵袭实验
: 基于阻抗检测的细胞分析技术,使得实时、不间断且无需标记的细胞监测成为可能。对数据流的后续分析可以揭示细胞间互作和细胞-药物反应的动力学,可以更好地理解其机理而无需做费时费力的多次终点法实验。 应用:利用划痕实验评估MCP抑制肿瘤细胞转移疗效 改性柑桔果胶(MCP)可以从柑桔的皮及果肉中提取到,是一种人体不易吸收的水溶性多糖复合物,其抗肿瘤转移的疗效正受到越来越多的关注。佐治亚大学的Gomillion博士利用实时定量阻抗(Maestro Z系统)实验去评估MCP抑制两种肿瘤细胞
,计数进入下室的细胞量可反映肿瘤细胞的迁移能力。 (4)肿瘤细胞侵袭实验 常用8.0、12.0 μm膜,原理与肿瘤细胞迁移实验类似。 2. 肿瘤细胞侵袭模型 用于研究肿瘤细胞侵袭能力的肿瘤细胞侵袭模型有如下几种(引自司徒镇强《细胞培养》): 2.1 体内癌细胞侵袭模型 2.1.1 皮下移植侵袭模型 2.1.2 肌肉内移植侵袭模型 2.1.3 腹腔内移植侵袭模型 2.1.4 小鼠肾包膜下移植侵袭模型 2.1.5 鼠睾丸包膜下移植侵袭模型
2.2.4.2 旋转摇动球体器官培养法 2.2.5 单层细胞侵袭实验模型 2.2.6 Transwell侵袭小室测定法可见,Transwell与侵袭实验之间并不能划等号,Transwell有多种应用,侵袭实验也有多种方法。所谓Transwell侵袭实验,其实是指 将Transwell这一技术应用于肿瘤细胞侵袭研究的一种实验。由于其简单易行、重复性好,因而得到了越来越广泛的应用,但不能认为研究肿瘤侵袭只有 Transwell一种方法
技术资料暂无技术资料 索取技术资料